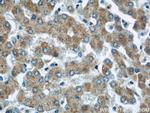
CHMP2B Antibody in Immunohistochemistry (Paraffin) (IHC (P))

Search
Proteintech
CHMP2B Polyclonal Antibody
{{$productOrderCtrl.translations['antibody.pdp.commerceCard.promotion.promotions']}}
{{$productOrderCtrl.translations['antibody.pdp.commerceCard.promotion.viewpromo']}}
{{$productOrderCtrl.translations['antibody.pdp.commerceCard.promotion.promocode']}}: {{promo.promoCode}} {{promo.promoTitle}} {{promo.promoDescription}}. {{$productOrderCtrl.translations['antibody.pdp.commerceCard.promotion.learnmore']}}

Please note: We are reviewing Western blot images included in the antibody testing data in our catalog, including those provided by third parties. Unless expressly labeled or annotated as “raw-unedited”, Western blot images included in the antibody testing data in our catalog may have been edited, optimized or otherwise adjusted for presentation.
产品信息
12527-1-AP
种属反应
已发表种属
宿主/亚型
分类
类型
抗原
偶联物
形式
浓度
规格
纯化类型
保存液
内含物
保存条件
运输条件
产品详细信息
Immunogen sequence: MASLFKKKT VDDVIKEQNR ELRGTQRAII RDRAALEKQE KQLELEIKKM AKIGNKEACK VLAKQLVHLR KQKTRTFAVS SKVTSMSTQT KVMNSQMKMA GAMSTTAKTM QAVNKKMDPQ KTLQTMQNFQ KENMKMEMTE EMINDTLDDI FDGSDDEEES QDIVNQVLDE IGIEISGKMA KAPSAARSLP SASTSKATIS DEEIERQLKA LGVD (1-213 aa encoded by BC001553)
靶标信息
CHMP2B, also known as CHMP2.5 or vacuolar protein-sorting-associated protein 2-2, is a 213 amino acid cytosolic protein. Widely expressed in brain, heart, skeletal muscle, small intestine, pancreas, lung, placenta and leukocytes, CHMP2B associates directly with CHMP2A and vps4 for the disassembly of the ESCRT-III complex. Defects in the gene encoding CHMP2B have been shown to cause chromosome 3-linked frontotemporal dementia (FTD3).
仅用于科研。不用于诊断过程。未经明确授权不得转售。
生物信息学
蛋白别名: Charged multivesicular body protein 2b; CHMP family; CHMP2b; chromatin modifying protein 2B; Chromatin-modifying protein 2b; hVps2-2
基因别名: 1190006E07Rik; Chmp2b; RGD1306781
UniProt ID: (Mouse) Q8BJF9
Entrez Gene ID: (Mouse) 68942, (Rat) 363720




